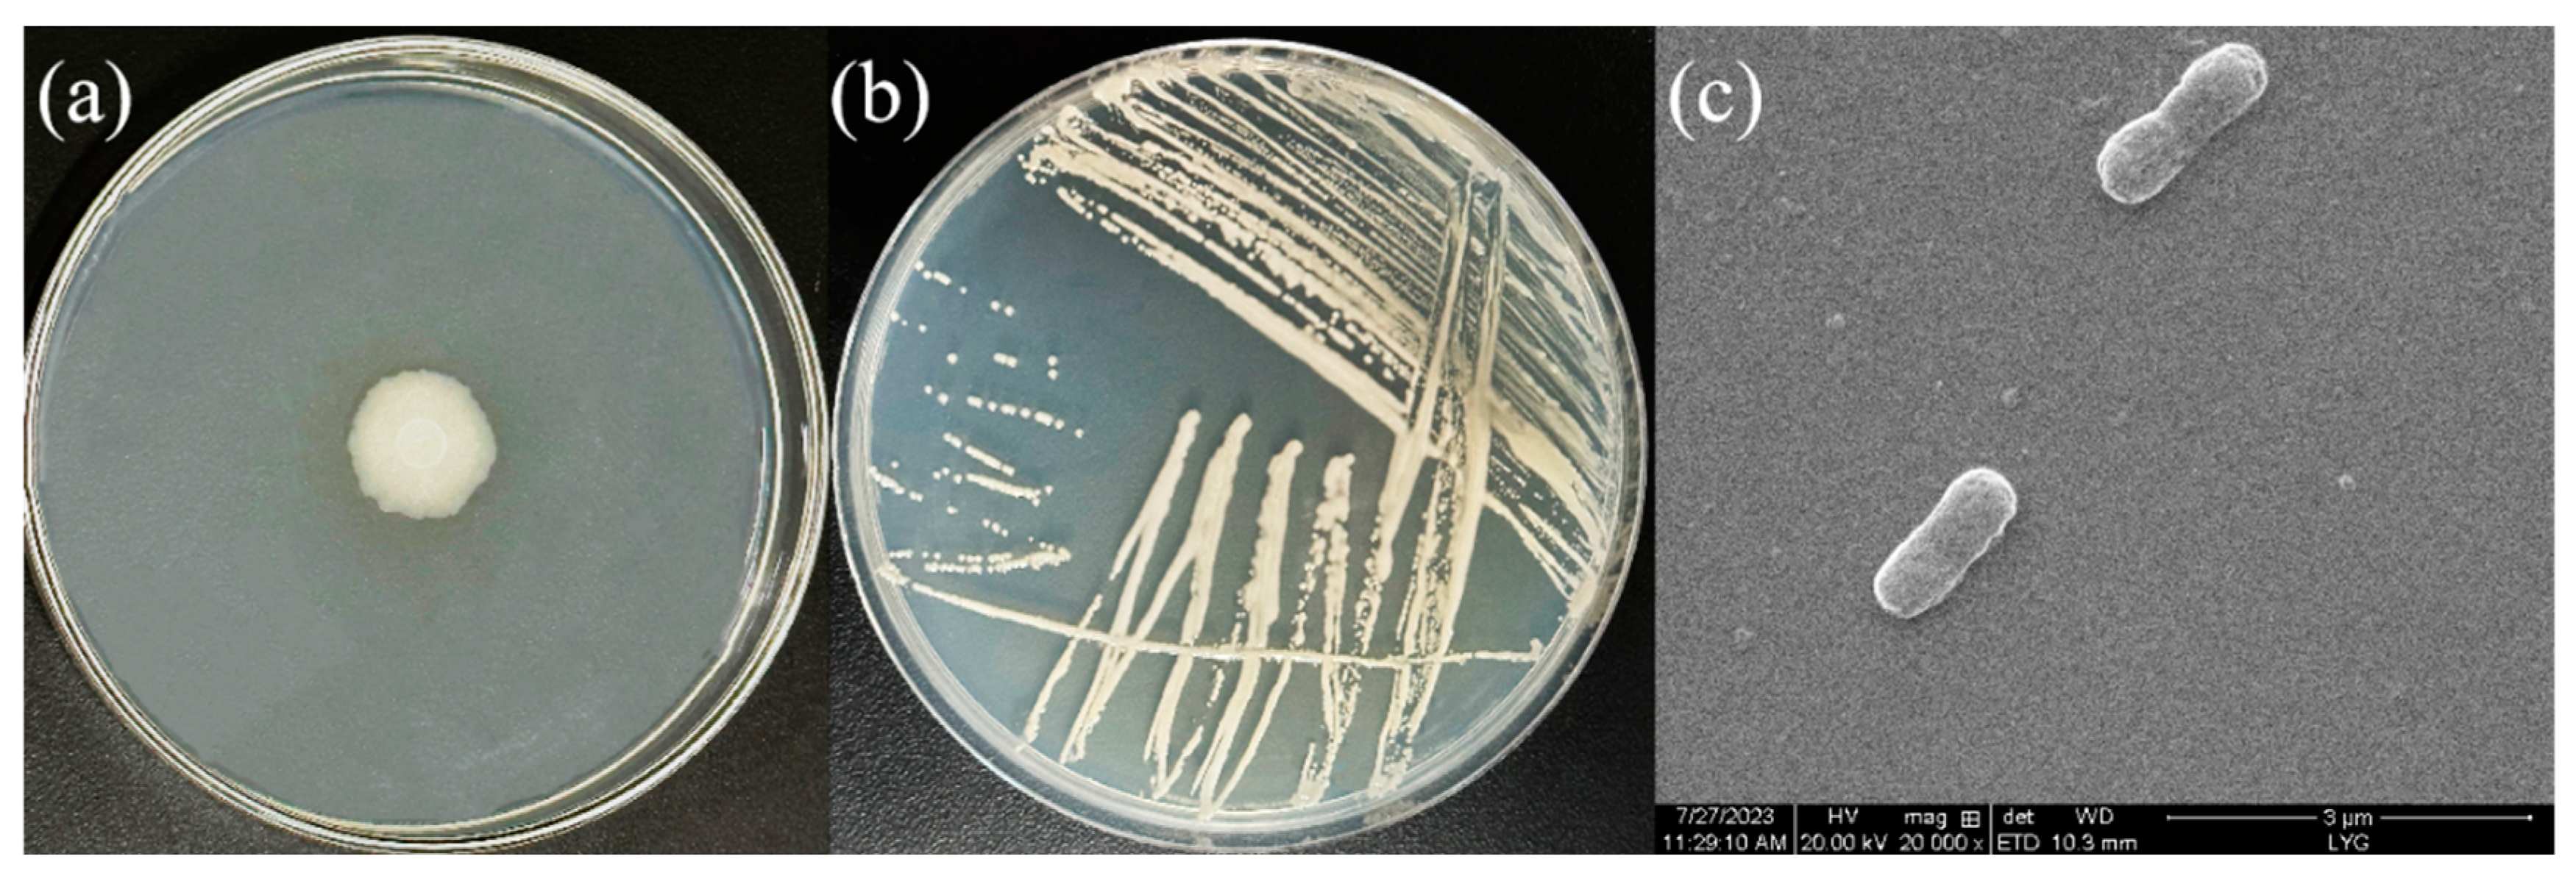
Water 16 00416 g001

Heterotrophic Nitrification–Aerobic Denitrification by Bacillus sp. L2: Mechanism of Denitrification and Strain Immobilization
Abstract
1. Introduction
2. Materials and Methods
2.1. Materials
2.1.1. Samples
2.1.2. Instruments and Reagents
2.1.3. Medium Preparation
2.2. Methods
2.2.1. Screening of Strain L2
2.2.2. Morphological Analysis and Identification of Strain L2
2.2.3. HN-AD Characteristics of Strain L2
2.2.4. Study of NH4+-N Removal Performance of Strain L2
2.2.5. Study of Denitrification Pathways in Strain L2
2.2.6. Immobilization of Strain L2
2.2.7. Analytical Methods
3. Results and Discussion
3.1. Morphological Characterization of Strain L2
3.2. Identification of Strain L2
3.3. HN-AD Characteristics of Strain L2
3.3.1. Heterotrophic Nitrification
3.3.2. Aerobic Denitrification
3.4. Effect of Mixed Nitrogen Sources on the Nitrification Function of Strain L2
3.5. Characterization of NH4+-N Removal by Strain L2
3.5.1. Effect of Carbon Source
3.5.2. Effect of C/N Ratio
3.5.3. Effect of pH
3.5.4. Effect of Salinity
3.5.5. Effect of Initial NH4+-N Concentration
3.6. Detection of Genes Related to Nitrogen Removal in HN-AD Strain L2
3.7. Application of Immobilized Strain L2 for Wastewater Treatment
4. Conclusions
Supplementary Materials
Author Contributions
Funding
Data Availability Statement
Conflicts of Interest
References
- Ke, X.; Liu, C.; Tang, S.-Q.; Guo, T.-T.; Pan, L.; Xue, Y.-P.; Zheng, Y.-G. Characterization of Acinetobacter indicus ZJB20129 for heterotrophic nitrification and aerobic denitrification isolated from an urban sewage treatment plant. Bioresour. Technol. 2021, 347, 126423. [Google Scholar] [CrossRef] [PubMed]
- Song, T.; Zhang, X.; Li, J.; Wu, X.; Feng, H.; Dong, W. A review of research progress of heterotrophic nitrification and aerobic denitrification microorganisms (HNADMs). Sci. Total. Environ. 2021, 801, 149319. [Google Scholar] [CrossRef] [PubMed]
- Wang, Y.; Zou, Y.-L.; Chen, H.; Lv, Y.-K. Nitrate removal performances of a new aerobic denitrifier, Acinetobacter haemolyticus ZYL, isolated from domestic wastewater. Bioprocess Biosyst. Eng. 2020, 44, 391–401. [Google Scholar] [CrossRef] [PubMed]
- Chen, J.; Xu, J.; Zhang, S.; Liu, F.; Peng, J.; Peng, Y.; Wu, J. Nitrogen removal characteristics of a novel heterotrophic nitrification and aerobic denitrification bacteria, Alcaligenes faecalis strain WT14. J. Environ. Manag. 2021, 282, 111961. [Google Scholar] [CrossRef] [PubMed]
- Mishra, S.; Singh, V.; Cheng, L.; Hussain, A.; Ormeci, B. Nitrogen removal from wastewater: A comprehensive review of biological nitrogen removal processes, critical operation parameters and bioreactor design. J. Environ. Chem. Eng. 2022, 10, 107387. [Google Scholar] [CrossRef]
- Wang, Q.K.; He, J.Z. Complete nitrogen removal via simultaneous nitrification and denitrification by a novel phosphate accumulating Thauera sp. strain SND5. Water Res. 2020, 185, 116300. [Google Scholar] [CrossRef]
- Andreadakis, D.; Noutsopoulos, C.; Fragkiskatos, G.; Mamais, D.; Misirli, T.; Argyropoulou, K.; Themeli, E.; Malamis, S. Inhibition of free nitrous acid and free ammonia on polyphosphate accumulating organisms: Evidence of insufficient phosphorus removal through nitritation-denitritation. J. Environ. Manag. 2021, 297, 113390. [Google Scholar] [CrossRef]
- Reino, C.; Carrera, J. Impact of the nitrifying community dynamics on the partial nitritation process performed by an AOB-enriched culture in a granular sludge airlift reactor. J. Environ. Chem. Eng. 2021, 9, 106691. [Google Scholar] [CrossRef]
- Iannacone, F.; Di Capua, F.; Granata, F.; Gargano, R.; Esposito, G. Shortcut nitrification-denitrification and biological phosphorus removal in acetate- and ethanol-fed moving bed biofilm reactors under microaerobic/aerobic conditions. Bioresour. Technol. 2021, 330, 124958. [Google Scholar] [CrossRef]
- He, X.; Sun, Q.; Xu, T.; Dai, M.; Wei, D. Removal of nitrogen by heterotrophic nitrification-aerobic denitrification of a novel halotolerant bacterium Pseudomonas mendocina TJPU04. Bioprocess Biosyst. Eng. 2019, 42, 853–866. [Google Scholar] [CrossRef]
- He, T.; Li, Z.; Sun, Q.; Xu, Y.; Ye, Q. Heterotrophic nitrification and aerobic denitrification by Pseudomonas tolaasii Y-11 without nitrite accumulation during nitrogen conversion. Bioresour. Technol. 2016, 200, 493–499. [Google Scholar] [CrossRef] [PubMed]
- Pan, Y.; Liu, D.F. Tapping the Potential of Wastewater Treatment with Direct Ammonia Oxidation (Dirammox). Environ. Sci. Technol. 2023, 57, 7106–7108. [Google Scholar] [CrossRef] [PubMed]
- Robertson, L.A.; Kuenen, J.G.J. Aerobic denitrification: A controversy revived. Arch. Microbiol. 1984, 139, 351–354. [Google Scholar] [CrossRef]
- Kang, X.; Zhao, X.; Song, X.; Wang, D.; Shi, G.; Duan, X.; Chen, X.; Shen, G. Nitrogen removal by a novel strain Priestia aryabhattai KX-3 from East Antarctica under alkaline pH and low-temperature conditions. Process. Biochem. 2023, 130, 674–684. [Google Scholar] [CrossRef]
- Zhou, H.; Cheng, L.; Xia, L.; Deng, G.; Zhang, Y.; Shi, X. Rapid simultaneous removal of nitrogen and phosphorous by a novel isolated Pseudomonas mendocina SCZ-2. Environ. Res. 2023, 231, 116062. [Google Scholar] [CrossRef]
- Jiang, G.; Liu, Y.; Liu, X.; Shen, Y.; Zhang, A.; Li, Z. Enhanced efficiency and mechanism of low-temperature biochar on simultaneous removal of nitrogen and phosphorus by combined heterotrophic nitrification-aerobic denitrification bacteria. Bioresour. Technol. 2023, 373, 128720. [Google Scholar] [CrossRef]
- Wang, Q.; Kong, J.; Liang, J.; El-Din, M.G.; Zhao, P.; Xie, W.; Chen, C. Nitrogen removal intensification of aerobic granular sludge through bioaugmentation with “heterotrophic nitrification-aerobic denitrification” consortium during petroleum wastewater treatment. Bioresour. Technol. 2022, 361, 127719. [Google Scholar] [CrossRef]
- Gu, X.; Leng, J.; Zhu, J.; Zhang, K.; Zhao, J.; Wu, P.; Xing, Q.; Tang, K.; Li, X.; Hu, B. Influence mechanism of C/N ratio on heterotrophic nitrification- aerobic denitrification process. Bioresour. Technol. 2021, 343, 126116. [Google Scholar] [CrossRef]
- Ma, F.; Sun, Y.; Li, A.; Zhang, X.; Yang, J. Activation of accumulated nitrite reduction by immobilized Pseudomonas stutzeri T13 during aerobic denitrification. Bioresour. Technol. 2015, 187, 30–36. [Google Scholar] [CrossRef]
- Nguyen, T.M.; Ha, P.T.; Le, T.T.H.; Phan, K.S.; Mai, T.T.T.; Hoang, P.H. Modification of expanded clay carrier for enhancing the immobilization and nitrogen removal capacity of nitrifying and denitrifying bacteria in the aquaculture system. J. Biosci. Bioeng. 2022, 134, 41–47. [Google Scholar] [CrossRef]
- Behin, J.; Amiri, P. A review of recent advances in airlift reactors technology with emphasis on environmental remediation. J. Environ. Manag. 2023, 335, 117560. [Google Scholar] [CrossRef]
- Guo, C.; Wang, Y.; Luo, Y.; Chen, X.; Lin, Y.; Liu, X. Effect of graphene oxide on the bioactivities of nitrifying and denitrifying bacteria in aerobic granular sludge. Ecotoxicol. Environ. Saf. 2018, 156, 287–293. [Google Scholar] [CrossRef] [PubMed]
- Hu, B.; Lu, J.; Qin, Y.; Zhou, M.; Tan, Y.; Wu, P.; Zhao, J. A critical review of heterotrophic nitrification and aerobic denitrification process: Influencing factors and mechanisms. J. Water Process Eng. 2023, 54, 103995. [Google Scholar] [CrossRef]
- Deng, M.; Zhao, X.; Senbati, Y.; Song, K.; He, X. Nitrogen removal by heterotrophic nitrifying and aerobic denitrifying bacterium Pseudomonas sp. DM02: Removal performance, mechanism and immobilized application for real aquaculture wastewater treatment. Bioresour. Technol. 2020, 322, 124555. [Google Scholar] [CrossRef] [PubMed]
- Dadrasnia, A.; Azirun, M.S.; Ismail, S.B. Optimal reduction of chemical oxygen demand and NH3-N from landfill leachate using a strongly resistant novel Bacillus salmalaya strain. BMC Biotechnol. 2017, 17, 85. [Google Scholar] [CrossRef] [PubMed]
- Cui, Y.; Cui, Y.W.; Huang, J.L. A novel halophilic Exiguobacterium mexicanum strain removes nitrogen from saline wastewater via heterotrophic nitrification and aerobic denitrification. Bioresour. Technol. 2021, 333, 125189. [Google Scholar] [CrossRef] [PubMed]
- Xia, L.; Li, X.; Fan, W.; Wang, J. Heterotrophic nitrification and aerobic denitrification by a novel Acinetobacter sp. ND7 isolated from municipal activated sludge. Bioresour. Technol. 2020, 301, 122749. [Google Scholar] [CrossRef]
- Lang, X.; Li, Q.; Ji, M.; Yan, G.; Guo, S. Isolation and niche characteristics in simultaneous nitrification and denitrification application of an aerobic denitrifier, Acinetobacter sp. YS2. Bioresour. Technol. 2020, 302, 122799. [Google Scholar] [CrossRef]
- Huang, F.; Pan, L.Q.; Lv, N.; Tang, X. Characterization of novel Bacillus strain N31 from mariculture water capable of halophilic heterotrophic nitrification-aerobic denitrification. J Biosci. Bioeng. 2017, 124, 564–571. [Google Scholar] [CrossRef]
- Liu, Y.; Ai, G.-M.; Wu, M.-R.; Li, S.-S.; Miao, L.-L.; Liu, Z.-P. Photobacterium sp. NNA4, an efficient hydroxylamine-transforming heterotrophic nitrifier/aerobic denitrifier. J. Biosci. Bioeng. 2019, 128, 64–71. [Google Scholar] [CrossRef]
- Motamedi, H.; Jafari, M. Screening Heterotrophic Ammonia Removal and Aerobic Denitrifying Bacteria from Wastewater of Ammonia Production Units of a Petrochemical Industry. Curr. Microbiol. 2020, 77, 2207–2214. [Google Scholar] [CrossRef] [PubMed]
- Jung, J.; Choi, S.; Jung, H.; Scow, K.M.; Park, W. Primers for amplification of nitrous oxide reductase genes associated with Firmicutes and Bacteroidetes in organic-compound-rich soils. Microbiology 2013, 159, 307–315. [Google Scholar] [CrossRef] [PubMed][Green Version]
- Roussel-Delif, L.; Tarnawski, S.; Hamelin, J.; Philippot, L.; Aragno, M.; Fromin, N. Frequency and diversity of nitrate reductase genes among nitrate-dissimilating pseudomonas in the rhizosphere of perennial grasses grown in field conditions. Microb. Ecol. 2005, 49, 63–72. [Google Scholar] [CrossRef] [PubMed]
- Padhi, S.K.; Tripathy, S.; Sen, R.; Mahapatra, A.S.; Mohanty, S.; Maiti, N.K. Characterisation of heterotrophic nitrifying and aerobic denitrifying Klebsiella pneumoniae CF-S9 strain for bioremediation of wastewater. Int. Biodeterior. Biodegrad. 2013, 78, 67–73. [Google Scholar] [CrossRef]
- Throbäck, I.N.; Enwall, K.; Jarvis, Å.; Hallin, S. Reassessing PCR primers targeting nirS, nirK and nosZ genes for community surveys of denitrifying bacteria with DGGE. FEMS Microbiol. Ecol. 2004, 49, 401–417. [Google Scholar] [CrossRef]
- Deng, M.; Li, L.; Dai, Z.; Senbati, Y.; Song, K.; He, X. Aerobic denitrification affects gaseous nitrogen loss in biofloc-based recirculating aquaculture system. Aquaculture 2020, 529, 735686. [Google Scholar] [CrossRef]
- Xu, N.; Liao, M.; Liang, Y.; Guo, J.; Zhang, Y.; Xie, X.; Fan, Q.; Zhu, Y. Biological nitrogen removal capability and pathways analysis of a novel low C/N ratio heterotrophic nitrifying and aerobic denitrifying bacterium (Bacillus thuringiensis strain WXN-23). Environ. Res. 2021, 195, 110797. [Google Scholar] [CrossRef] [PubMed]
- Liu, Y.; Wang, Y.; Li, Y.; An, H.; Lv, Y. Nitrogen removal characteristics of heterotrophic nitrification-aerobic denitrification by Alcaligenes faecalis C16. Chin. J. Chem. Eng. 2015, 23, 827–834. [Google Scholar] [CrossRef]
- Yang, J.-R.; Wang, Y.; Chen, H.; Lyu, Y.-K. Ammonium removal characteristics of an acid-resistant bacterium Acinetobacter sp. JR1 from pharmaceutical wastewater capable of heterotrophic nitrification-aerobic denitrification. Bioresour. Technol. 2018, 274, 56–64. [Google Scholar] [CrossRef]
- Sun, Z.; Lv, Y.; Liu, Y.; Ren, R. Removal of nitrogen by heterotrophic nitrification-aerobic denitrification of a novel metal resistant bacterium Cupriavidus sp S1. Bioresour. Technol. 2016, 220, 142–150. [Google Scholar] [CrossRef]
- Yang, L.; Ren, Y.-X.; Liang, X.; Zhao, S.-Q.; Wang, J.-P.; Xia, Z.-H. Nitrogen removal characteristics of a heterotrophic nitrifier Acinetobacter junii YB and its potential application for the treatment of high-strength nitrogenous wastewater. Bioresour. Technol. 2015, 193, 227–233. [Google Scholar] [CrossRef] [PubMed]
- Barathi, S.; Meng, Y.; Yu, Z.; Ni, S.-Q.; Meng, F. Roles of nitrite in mediating the composition and metacommunity of multispecies biofilms. J. Water Process. Eng. 2021, 40, 101764. [Google Scholar] [CrossRef]
- Zhang, Q.; Zhu, Y.; Yuan, C.; Zhang, C.; Cui, M.; Zhao, T. Nitrogen removal and mechanism of an extremely high-ammonia tolerant heterotrophic nitrification-aerobic denitrification bacterium Alcaligenes faecalis TF-1. Bioresour. Technol. 2022, 361, 127643. [Google Scholar] [CrossRef] [PubMed]
- Shrimali, M.; Singh, K.P. New methods of nitrate removal from water. Environ. Pollut. 2001, 112, 351–359. [Google Scholar] [CrossRef] [PubMed]
- Wei, B.; Luo, X.; Ma, W.; Lv, P. Biological nitrogen removal and metabolic characteristics of a novel cold-resistant heterotrophic nitrification and aerobic denitrification Rhizobium sp. WS7. Bioresour. Technol. 2022, 362, 127756. [Google Scholar] [CrossRef] [PubMed]
- Wen, G.; Wang, T.; Li, K.; Wang, H.; Wang, J.; Huang, T. Aerobic denitrification performance of strain Acinetobacter johnsonii WGX-9 using different natural organic matter as carbon source: Effect of molecular weight. Water Res. 2019, 164, 114956. [Google Scholar] [CrossRef]
- Hang, Q.; Wang, H.; Chu, Z.; Ye, B.; Li, C.; Hou, Z. Application of plant carbon source for denitrification by constructed wetland and bioreactor: Review of recent development. Environ. Sci. Pollut. Res. 2016, 23, 8260–8274. [Google Scholar] [CrossRef]
- Wang, T.; Dang, Q.; Liu, C.; Yan, J.; Fan, B.; Cha, D.; Yin, Y.; Zhang, Y. Heterotrophic nitrogen removal by a newly-isolated alkalitolerant microorganism, Serratia marcescens W5. Bioresour. Technol. 2016, 211, 618–627. [Google Scholar] [CrossRef]
- Song, K.; Gao, Y.; Yang, Y.; Guo, B.-Q.; Wang, Y.-Z. Performance of simultaneous carbon and nitrogen removal of high-salinity wastewater in heterotrophic nitrification-aerobic denitrification mode. J. Environ. Chem. Eng. 2023, 11, 109682. [Google Scholar] [CrossRef]
- Gao, F.; Zhang, H.M.; Yang, F.L.; Qiang, H.; Li, H.; Zhang, R. Study of an innovative anaerobic (A)/oxic (O)/anaerobic (A) bioreactor based on denitrification-anammox technology treating low C/N municipal sewage. Chem. Eng. J. 2013, 232, 65–73. [Google Scholar] [CrossRef]
- Zhang, Z.; Zhang, C.; Yang, Y.; Zhang, Z.; Tang, Y.; Su, P.; Lin, Z. A review of sulfate-reducing bacteria: Metabolism, influencing factors and application in wastewater treatment. J. Clean. Prod. 2022, 376, 134109. [Google Scholar] [CrossRef]
- Zhang, M.; Li, A.; Yao, Q.; Wu, Q.; Zhu, H. Nitrogen removal characteristics of a versatile heterotrophic nitrifying-aerobic denitrifying bacterium, Pseudomonas bauzanensis DN13-1, isolated from deep-sea sediment. Bioresour. Technol. 2019, 305, 122626. [Google Scholar] [CrossRef] [PubMed]
- Vijay, A.; Arora, S.; Gupta, S.; Chhabra, M. Halophilic starch degrading bacteria isolated from Sambhar Lake, India, as potential anode catalyst in microbial fuel cell: A promising process for saline water treatment. Bioresour. Technol. 2018, 256, 391–398. [Google Scholar] [CrossRef]
- He, H.; Chen, Y.; Li, X.; Cheng, Y.; Yang, C.; Zeng, G. Influence of salinity on microorganisms in activated sludge processes: A review. Int. Biodeterior. Biodegrad. 2016, 119, 520–527. [Google Scholar] [CrossRef]
- Guo, Y.; Zhou, X.; Li, Y.; Li, K.; Wang, C.; Liu, J.; Yan, D.; Liu, Y.; Yang, D.; Xing, J. Heterotrophic nitrification and aerobic denitrification by a novel Halomonas campisalis. Biotechnol. Lett. 2013, 35, 2045–2049. [Google Scholar] [CrossRef] [PubMed]
- Duan, J.; Fang, H.; Su, B.; Chen, J.; Lin, J. Characterization of a halophilic heterotrophic nitrification-aerobic denitrification bacterium and its application on treatment of saline wastewater. Bioresour. Technol. 2015, 179, 421–428. [Google Scholar] [CrossRef] [PubMed]
- Liu, X.; Zhang, Q.; Yang, X.; Wu, D.; Li, Y.; Di, H. Isolation and characteristics of two heterotrophic nitrifying and aerobic denitrifying bacteria, Achromobacter sp. strain HNDS-1 and Enterobacter sp. strain HNDS-6. Environ. Res. 2023, 220, 115240. [Google Scholar] [CrossRef]
- Zhang, M.; Pan, L.; Liu, L.; Su, C.; Dou, L.; Su, Z.; He, Z. Phosphorus and nitrogen removal by a novel phosphate-accumulating organism, Arthrobacter sp. HHEP5 capable of heterotrophic nitrification-aerobic denitrification: Safety assessment, removal characterization, mechanism exploration and wastewater treatment. Bioresour. Technol. 2020, 312, 123633. [Google Scholar] [CrossRef]
- Gao, H.; Li, C.; Ramesh, B.; Hu, N. Cloning, purification and characterization of novel Cu-containing nitrite reductase from the Bacillus firmus GY-49. World J. Microbiol. Biotechnol. 2018, 34, 10. [Google Scholar] [CrossRef]
- Chen, J.; Gu, S.; Hao, H.; Chen, J. Characteristics and metabolic pathway of Alcaligenes sp TB for simultaneous heterotrophic nitrification-aerobic denitrification. Appl. Microbiol. Biotechnol. 2016, 100, 9787–9794. [Google Scholar] [CrossRef]

| Blank | L2 | L2 + C | PSK + C | |
|---|---|---|---|---|
| Real pesticide wastewater (mL) | 100 | 100 | 100 | 100 |
| Added carbon source | - | - | + | + |
| Inoculated amount of strain L2 (%) | 0 | 10 | 10 | 0 |
| Cycle number | 3 | 3 | 3 | 3 |
Disclaimer/Publisher’s Note: The statements, opinions and data contained in all publications are solely those of the individual author(s) and contributor(s) and not of MDPI and/or the editor(s). MDPI and/or the editor(s) disclaim responsibility for any injury to people or property resulting from any ideas, methods, instructions or products referred to in the content. |
© 2024 by the authors. Licensee MDPI, Basel, Switzerland. This article is an open access article distributed under the terms and conditions of the Creative Commons Attribution (CC BY) license (https://creativecommons.org/licenses/by/4.0/).
Share and Cite
Li, Q.; He, Y.; Wang, B.; Weng, N.; Zhang, L.; Wang, K.; Tian, F.; Lyu, M.; Wang, S. Heterotrophic Nitrification–Aerobic Denitrification by Bacillus sp. L2: Mechanism of Denitrification and Strain Immobilization. Water 2024, 16, 416. https://doi.org/10.3390/w16030416
Li Q, He Y, Wang B, Weng N, Zhang L, Wang K, Tian F, Lyu M, Wang S. Heterotrophic Nitrification–Aerobic Denitrification by Bacillus sp. L2: Mechanism of Denitrification and Strain Immobilization. Water. 2024; 16(3):416. https://doi.org/10.3390/w16030416
Chicago/Turabian StyleLi, Qiang, Yuehui He, Boyan Wang, Nanhai Weng, Lei Zhang, Kaichun Wang, Fengrong Tian, Mingsheng Lyu, and Shujun Wang. 2024. "Heterotrophic Nitrification–Aerobic Denitrification by Bacillus sp. L2: Mechanism of Denitrification and Strain Immobilization" Water 16, no. 3: 416. https://doi.org/10.3390/w16030416
APA StyleLi, Q., He, Y., Wang, B., Weng, N., Zhang, L., Wang, K., Tian, F., Lyu, M., & Wang, S. (2024). Heterotrophic Nitrification–Aerobic Denitrification by Bacillus sp. L2: Mechanism of Denitrification and Strain Immobilization. Water, 16(3), 416. https://doi.org/10.3390/w16030416








